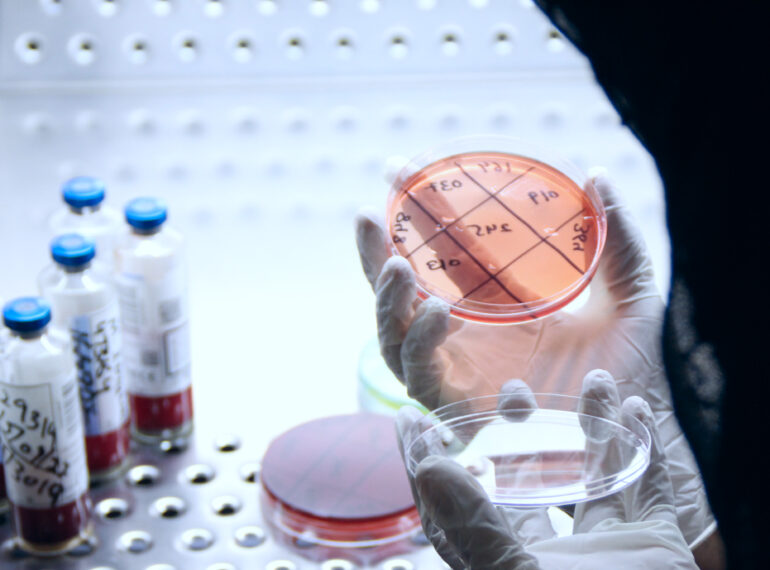

{"cpt":"service","style":"1","columns":"3","show":60,"from_category":["diagnostic-services"],"order":"DESC","orderby":"none"}

MRI
It’s the perfect choice for patients who feel anxious in enclosed spaces,

Electroencephalography (EEG)
Electroencephalography (EEG) is a non-invasive test that records electrical activity in the brain to diagnose conditions like epilepsy,

Electromyography (EMG)
Electromyography (EMG) is a diagnostic test that evaluates muscle activity and nerve function.

Nerve Conduction Study (NCS)
A Nerve Conduction Study (NCS) measures the speed and strength of electrical signals in nerves.

Spirometry
Spirometry is a simple, non-invasive lung function test that measures how well you breathe.

Endoscopy
CDC provides high-precision Endoscopy Services for accurate internal medical examinations.

Multi-Slice CT Scan
Our Multi-Slice CT Scan provides high-resolution, 3D imaging for quick and accurate diagnosis.

DR‑CR X‑Ray
Our DR (Digital Radiography) & CR (Computed Radiography) X-Ray services provide clear,

Interventional Radiology
Our DR (Digital Radiography) & CR (Computed Radiography) X-Ray services provide clear,

Dental Radiography
Our Dental Radiography services provide high-resolution digital X-rays for accurate diagnosis and treatment planning.

Ultrasound
Our Ultrasound services provide high-quality, real-time imaging for diagnosing and monitoring various medical conditions.

DEXA Scan
Our DEXA Scan (Dual-Energy X-ray Absorptiometry) provides a highly accurate measurement of bone density,

Clinical Chemistry
At CDC Diagnostic Centre, our Clinical Chemistry department specializes in advanced biochemical testing to evaluate body functions.

Hematology
Our Hematology Lab at CDC specializes in detailed blood analysis to diagnose various blood-related disorders.

Histopathology
Our Histopathology Lab at CDC specializes in microscopic examination of tissue samples to detect diseases.

Immunology
The Immunology Lab at CDC specializes in immune system assessments to diagnose autoimmune diseases, allergies, and immune deficiencies.

Clinical Pathology
The Clinical Pathology Lab at CDC provides comprehensive diagnostic testing for blood, urine, and body fluids.
Microbiology
The Microbiology Lab at CDC specializes in bacteria, viruses, fungi, and parasite testing.

Molecular Biology
The Molecular Biology Lab at CDC specializes in DNA, RNA, and genetic testing for precise disease detection.

Parasitology
The Parasitology Lab at CDC specializes in detecting and diagnosing parasitic infections.

Special Chemistry
The Special Pathology Lab at CDC focuses on advanced disease diagnosis and tissue analysis.

Echocardiography (Echo)
Echocardiography, or Echo, is a non-invasive ultrasound test that provides a detailed image of your heart’s structure and function.

Electrocardiogram (ECG)
An Electrocardiogram (ECG or EKG) is a simple, non-invasive test that records the electrical activity of your heart.

Exercise Tolerance Test (ETT)
An Exercise Tolerance Test (ETT), also known as a Stress Test, evaluates how your heart responds to physical activity.

Holter Monitoring Test
The Holter Monitoring Test is a continuous ECG recording that tracks your heart’s activity over 24 to 48 hours or longer.
